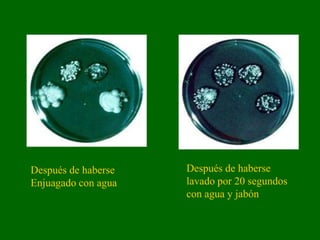
Después de haberse   Después de haberse
Enjuagado con agua   lavado por 20 segundos
                     con agua y jabón

Las buenas prácticas de manufactura (GMP) son regulaciones obligatorias orientadas a reducir peligros físicos, químicos o microbiológicos que puedan causar daño al consumidor. Las GMP exigen que los alimentos estén libres de adulteración, la cual incluye que los alimentos contengan sustancias venenosas, estén descompuestos o se hayan preparado sin condiciones sanitarias. Factores como la humedad, temperatura, tiempo y nutrientes afectan el crecimiento microbiano que puede dañar la calidad y seg

![(a) Mantenimiento general
Edificios, accesorios fijos, y otras instalaciones
físicas de la planta tienen que estar en
suficiente reparación para prevenir que se
adulteren los alimentos según el significado de
la ley [el acta].
La limpieza y desinfección de los utensilios y
equipos será conducido en una manera que
proteja contra la contaminación de los
alimentos, materiales de empaque para
alimentos, y superficies de contacto de
alimentos.](https://image.slidesharecdn.com/bpm-110913212635-phpapp02/85/Bpm-138-320.jpg)





















































![(a) Materia prima y otros
ingredientes-3
(2) La materia prima y otros ingredientes no
tienen que contener:
niveles de microorganismos que puedan producir
un envenenamiento u otras enfermedades que
afecte a los los seres humanos, o estos tienen que
ser pasteurizados o tratados de otra manera
durante las operaciones de manufactura para que
ya no contengan niveles que causen que el
producto sea adulterado según el significado de la
ley [el acta].](https://image.slidesharecdn.com/bpm-110913212635-phpapp02/85/Bpm-192-320.jpg)
![(a) Materia prima y otros
ingredientes-4
(3) La materia prima y otros ingredientes
susceptibles a la contaminación con
aflatoxinas u otras toxinas naturales tienen que
cumplir con:
los reglamentos,
guías,
niveles de acción [para sustancias venenosas y
peligrosas] actuales de la Administración de Drogas
y Alimentos antes que estos materiales o
ingredientes sean incorporados al producto final.
.](https://image.slidesharecdn.com/bpm-110913212635-phpapp02/85/Bpm-193-320.jpg)



![(a) Materia prima y otros
ingredientes-8
(5) La materia prima, otros ingredientes, y
producto reprocesado tienen que ser
mantenidos a granel, o en contenedores
diseñados y construidos para protegerlos
contra la contaminación y tienen que ser
mantenidos a temperaturas y humedad relativa
adecuadas para prevenir que los alimentos
sean adulterados según el significado de la ley
[el acta]. Los materiales destinados para ser
reprocesados serán identificados como tales.](https://image.slidesharecdn.com/bpm-110913212635-phpapp02/85/Bpm-197-320.jpg)





![(b) Operaciones de
manufactura-4
Controles que pueden realizarse
tiempo,
temperatura,
humedad,
aw [actividad de agua],
pH,
presión,
velocidad de flujo,](https://image.slidesharecdn.com/bpm-110913212635-phpapp02/85/Bpm-203-320.jpg)





![(b) Operaciones de
manufactura-10
(4) Medidas tales como:
la esterilización,
irradiación,
pasteurización,
congelamiento,
refrigeración,
control de pH
control del aw [actividad de agua]
que son tomadas para destruir o prevenir el crecimiento de
microorganismos indeseables, particularmente esos que son
significativos a la salud pública, tienen que ser adecuados bajo
las condiciones de manufactura, manejo, y distribución para
prevenir que los alimentos sean adulterados.](https://image.slidesharecdn.com/bpm-110913212635-phpapp02/85/Bpm-209-320.jpg)



![(b) Operaciones de
manufactura-14
(9)
Alimentos,
materia prima,
y otros ingredientes que estén adulterados según el
significado del acta
Tienen que ser dispuestos de tal manera que protejan contra
la contaminación de otros alimentos.
Si los alimentos adulterados pueden ser re- procesados, esto
tiene que hacerse con un método que se haya demostrado ser
efectivo o tienen que ser reexaminados y demostrado no ser
adulterado según el significado de la ley [el acta] antes de ser
incorporado en otros alimentos.](https://image.slidesharecdn.com/bpm-110913212635-phpapp02/85/Bpm-213-320.jpg)





















































































